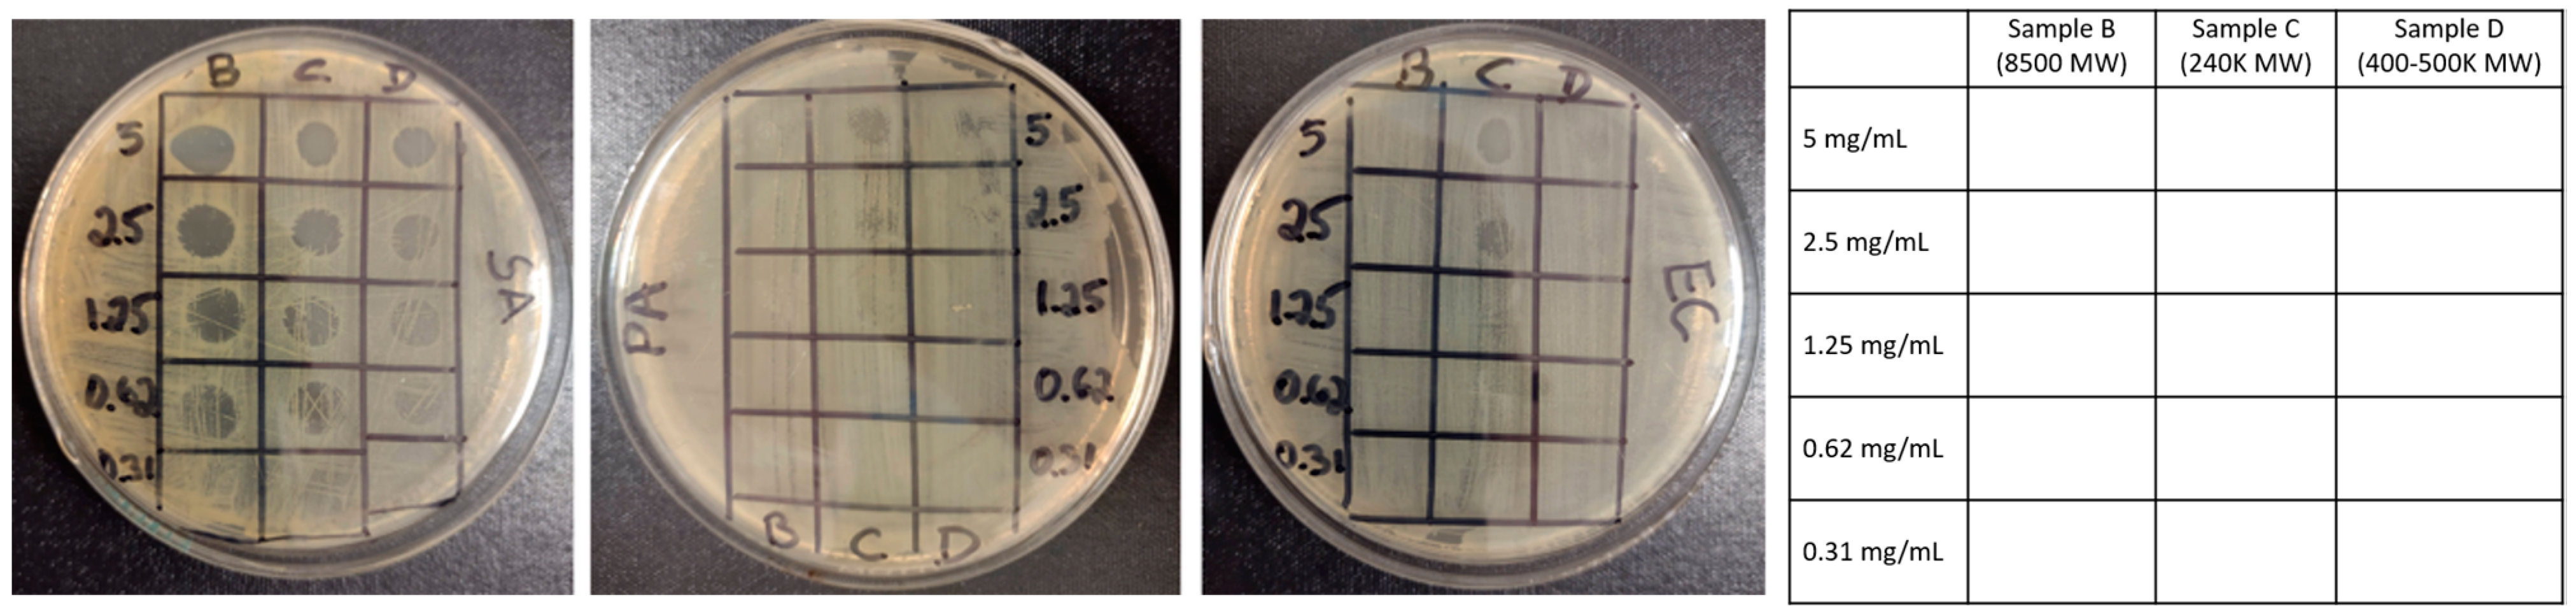
Polymers 15 00865 g005

Carboxylated Cellulose Nanocrystals Decorated with Varying Molecular Weights of Poly(diallyldimethylammonium chloride) as Sustainable Antibacterial Agents
Abstract
:1. Introduction
2. Materials and Methods
2.1. Materials and Reagents
2.2. Preparation of cCNCs and cCNCs Coated with Different Molecular Weights of PDDA
2.2.1. Preparation of cCNCs
2.2.2. Synthesis of cCNCs–PDDA
2.3. Characterization of cCNC–PDDA Samples
2.3.1. Fourier Transform Infrared (FTIR) Spectroscopy
2.3.2. Dynamic Light Scattering (DLS) and Zeta Potential
2.3.3. Elemental Analysis
2.3.4. Transmission Electron Microscopy (TEM)
2.3.5. Thermogravimetric Analysis (TGA)
2.4. Antibacterial Studies
2.4.1. Bacterial Lawn Inhibition Assay
2.4.2. Determination of Inhibitory Concentration
3. Results and Discussion
3.1. Design, Synthesis, and Characterization of cCNCs–PDDA
3.2. Assessment of the Antibacterial Properties of Cationic cCNC–PDDA Samples
4. Conclusions
Supplementary Materials
Author Contributions
Funding
Institutional Review Board Statement
Data Availability Statement
Acknowledgments
Conflicts of Interest
References
- Jones, K.E.; Patel, N.G.; Levy, M.A.; Storeygard, A.; Balk, D.; Gittleman, J.L.; Daszak, P. Global trends in emerging infectious diseases. Nature 2008, 451, 990–993. [Google Scholar] [CrossRef]
- Anisimov, A.P.; Amoako, K.K. Treatment of plague: Promising alternatives to antibiotics. J. Med. Microbiol. 2006, 55, 1461–1475. [Google Scholar]
- Beyth, N.; Houri-Haddad, Y.; Domb, A.; Khan, W.; Hazan, R. Alternative antimicrobial approach: Nano-antimicrobial materials. Evid. Based Complement. Alternat. Med. 2015, 2015, 246012. [Google Scholar]
- Hemeg, H.A. Nanomaterials for alternative antibacterial therapy. Int. J. Nanomed. 2017, 12, 8211–8225. [Google Scholar] [CrossRef]
- Makabenta, J.M.V.; Nabawy, A.; Li, C.H. Nanomaterial-based therapeutics for antibiotic-resistant bacterial infections. Nat. Rev. Microbiol. 2021, 19, 23–36. [Google Scholar]
- Chernousova, S.; Epple, M. Silver as antibacterial agent: Ion, nanoparticle, and metal. Angew. Chem. Int. Ed. 2013, 52, 1636–1653. [Google Scholar] [CrossRef]
- Malzahn, K.; Jamieson, W.D.; Dröge, M.; Mailänder, V.; Jenkins, A.; Weiss, C.K.; Landfester, K. Advanced dextran based nanogels for fighting Staphylococcus aureus infections by sustained zinc release. J. Mater. Chem. B 2014, 2, 2175–2183. [Google Scholar] [CrossRef]
- Zheng, W.; Jia, Y.; Zhao, Y.; Zhang, J.; Xie, Y.; Wang, L.; Zhao, X.; Liu, X.; Tang, R.; Chen, W.; et al. Reversing bacterial resistance to gold nanoparticles by size Modulation. Nano Lett. 2021, 21, 1992–2000. [Google Scholar]
- Bogdanovic, U.; Lazic, V.; Vodnik, V.; Budimir, M.; Markovic, Z.; Dimitrijevic, S. Copper nanoparticles with high antimicrobial activity. Mater. Lett. 2014, 128, 75–78. [Google Scholar]
- Yuan, H.; Liu, Z.; Liu, L.; Lv, F.; Wang, Y.; Wang, S. Cationic conjugated polymers for discrimination of microbial pathogens. Adv. Mater. 2014, 26, 4333–4338. [Google Scholar] [CrossRef]
- Wang, Y.; Chen, H.; Li, M.; Hu, R.; Lv, F.; Liu, L.; Wang, S. Synthesis of a new cationic non-conjugated polymer for discrimination of microbial pathogens. Polym. Chem. 2016, 7, 6699–6702. [Google Scholar] [CrossRef]
- Bai, H.; Zhang, H.; Hu, R.; Chen, H.; Lv, F.; Liu, L.; Wang, S. Supramolecular Conjugated Polymer Systems with Controlled Antibacterial Activity. Langmuir 2017, 33, 1116–1120. [Google Scholar]
- Xin, Q.; Shah, H.; Nawaz, A.; Xie, W.; Akram, M.Z.; Batool, A.; Tian, L.; Jan, S.U.; Boddula, R.; Guo, B.; et al. Antibacterial carbon-based nanomaterials. Adv. Mater. 2019, 31, 1804838. [Google Scholar]
- Ma, J.; Li, K.; Gu, S. Selective strategies for antibacterial regulation of nanomaterials. RSC Adv. 2022, 12, 4852–4864. [Google Scholar] [CrossRef]
- Habibi, Y.; Lucia, L.A.; Rojas, O.J. Cellulose nanocrystals: Chemistry, self-assembly, and applications. Chem. Rev. 2010, 110, 3479–3500. [Google Scholar] [CrossRef]
- Sunasee, R.; Hemraz, U.D.; Ckless, K. Cellulose nanocrystals: A versatile nanoplatform for emerging biomedical applications. Expert Opin. Drug. Deliv. 2016, 13, 1243–1256. [Google Scholar] [CrossRef]
- Sunasee, R. Nanocellulose: Preparation, Functionalization and Applications. In Comprehensive Glycoscience, 2nd ed.; Barchi, J.J., Jr., Ed.; Elsevier: Amsterdam, The Netherlands, 2021; Volume 4, pp. 506–537. [Google Scholar]
- Eyley, S.; Thielemans, W. Surface chemical modification of cellulose nanocrystals. Nanoscale 2014, 6, 7764–7779. [Google Scholar] [CrossRef] [Green Version]
- Sunasee, R.; Hemraz, U.D. Synthetic strategies for the fabrication of cationic surface-modified cellulose nanocrystals. Fibers 2018, 6, 15. [Google Scholar] [CrossRef]
- Lizundia, E.; Goikuria, U.; Vilas, J.L.; Cristofaro, F.; Bruni, G.; Fortunati, E.; Armentano, I.; Visai, L.; Torre, L. Metal nanoparticles embedded in cellulose nanocrystal based films: Material properties and post-use analysis. Biomacromolecules 2018, 19, 2618–2628. [Google Scholar]
- Lefatshe, K.; Muiva, C.M.; Kebaabetswe, L.P. Extraction of nanocellulose and in-situ casting of ZnO/cellulose nanocomposite with enhanced photocatalytic and antibacterial activity. Carbohydr. Polym. 2017, 164, 301–308. [Google Scholar]
- Baldelli, A.; Etayash, H.; Oguzlu, H.; Mandal, R.; Jiang, F.; Hancock, R.E.W.; Pratap-Singh, A. Antimicrobial properties of spray-dried cellulose nanocrystals and metal oxide-based nanoparticles-in-microspheres. Chem. Eng. J. Adv. 2022, 10, 100273. [Google Scholar] [CrossRef]
- Poonguzhali, R.; Basha, S.K.; Kumari, V.S. Synthesis and characterization of chitosan-PVP-nanocellulose composites for in-vitro wound dressing application. Int. J. Biol. Macromol. 2017, 105, 111–120. [Google Scholar] [CrossRef]
- Mujtaba, M.; Salaberria, A.M.; Andres, M.A.; Kaya, M.; Gunyakti, A.; Labidi, J. Utilization of flax (Linumusitatissimum) cellulose nanocrystals as reinforcing material for chitosan films. Int. J. Biol. Macromol. 2017, 104, 944–952. [Google Scholar]
- Tong, W.Y.; bin Abdullah, A.Y.K.; binti Rozman, N.A.S.; bin Wahid, M.I.A.; Hossain, M.S.; Ring, L.C.; Lazim, Y.; Tan, W.-N. Antimicrobial wound dressing film utilizing cellulose nanocrystal as drug delivery system for curcumin. Cellulose 2018, 25, 631–638. [Google Scholar] [CrossRef]
- de Castro, D.O.; Tabary, N.; Martel, B.; Gandini, A.; Belgacem, N.; Bras, J. Controlled release of carvacrol and curcumin: Bio-based food packaging by synergism action of TEMPO-oxidized cellulose nanocrystals and cyclodextrin. Cellulose 2018, 25, 1249–1263. [Google Scholar] [CrossRef]
- De Castro, D.O.; Bras, J.; Gandini, A.; Belgacem, N. Surface grafting of cellulose nanocrystals with natural antimicrobial rosin mixture using a green process. Carbohydr. Polym. 2016, 137, 1–8. [Google Scholar] [CrossRef]
- Jebali, A.; Hekmatimoghaddam, S.; Behzadi, A.; Rezapor, I.; Mohammadi, B.H.; Jasemizad, T.; Yasini, S.A.; Javadzadeh, M.; Amiri, A.; Soltani, M.; et al. Antimicrobial activity of nanocellulose conjugated with allicin and lysozyme. Cellulose 2013, 20, 2897–2907. [Google Scholar] [CrossRef]
- Kupnik, K.; Primožiˇc, M.; Kokol, V.; Leitgeb, M. Nanocellulose in drug delivery and antimicrobially active materials. Polymers 2020, 12, 2825. [Google Scholar] [CrossRef]
- Liu, Y.; Strauss, J.; Camesano, T.A. Adhesion forces between Staphylococcus epidermidis and surfaces bearing self-assembled monolayers in the presence of model proteins. Biomaterials 2008, 29, 4374–4382. [Google Scholar]
- Feese, E.; Sadeghifar, H.; Gracz, H.S.; Argyropoulos, D.S.; Ghiladi, R.A. Photobactericidal porphyrin-cellulose nanocrystals: Synthesis, characterization, and antimicrobial properties. Biomacromolecules 2011, 12, 3528–3539. [Google Scholar]
- Bespalova, Y.; Kwon, D.; Vasanthan, N. Surface modification and antimicrobial properties of cellulose nanocrystals. J. Appl. Polym. Sci. 2017, 134, 44789. [Google Scholar]
- Tang, J.; Song, Y.; Tanvir, S.; Anderson, W.A.; Berry, R.M.; Tam, K.C. Polyrhodanine coated cellulose nanocrystals: A sustainable antimicrobial agent. ACS Sustain. Chem. Eng. 2015, 3, 1801–1809. [Google Scholar]
- Lam, E.; Hemraz, U.H. Preparation and Surface Functionalization of Carboxylated Cellulose Nanocrystals. Nanomaterials 2021, 11, 1641. [Google Scholar] [CrossRef]
- Wandrey, C.; Hernandez-Barajas, J.; Hunkeler, D. Diallyldimethylammonium chloride and its polymers. Adv. Polym. Sci. 1999, 145, 123–183. [Google Scholar]
- Sanches, L.M.; Petri, D.F.S.; de Melo Carrasco, L.D.; Carmona-Ribeiro, A.M. The antimicrobial activity of free and immobilized poly (diallyldimethylammonium) chloride in nanoparticles of poly (methylmethacrylate). J. Nanobiotechnol. 2015, 13, 58. [Google Scholar]
- Leung, A.C.W.; Hrapovic, S.; Lam, E.; Liu, Y.; Male, K.B.; Mahmoud, K.A.; Luong, J.H.T. Characteristics and properties of carboxylated cellulose nanocrystals prepared from a novel one-step procedure. Small 2011, 7, 302–305. [Google Scholar] [CrossRef] [Green Version]
- Pinto, A.H.; Taylor, J.K.; Chandradat, R.; Lam, E.; Liu, Y.; Leung, A.C.W.; Keating, M.; Sunasee, R. Wood-based cellulose nanocrystals as adsorbent of cationic toxic dye, Auramine O, for water treatment. J. Environ. Chem. Eng. 2020, 8, 104187. [Google Scholar] [CrossRef]
- Dong, L.; Zhang, X.; Ren, S.; Lei, T.; Sun, X.; Qic, Y.; Wu, Q. Poly(diallyldimethylammonium chloride)–cellulose nanocrystals supported Au nanoparticles for nonenzymatic glucose sensing. RSC Adv. 2016, 6, 6436–6442. [Google Scholar] [CrossRef]
- Lam, E.; Hrapovic, S.; Majid, E.; Chong, J.H.; Luong, J.H. Catalysis using gold nanoparticles decorated on nanocrystalline cellulose. Nanoscale 2012, 4, 997–1002. [Google Scholar]
- Bhattacharjee, S. DLS and zeta potential—What they are and what they are not? J. Control. Release 2016, 235, 337–351. [Google Scholar] [CrossRef]
- Vanderfleet, O.M.; Cranston, E.D. Production routes to tailor the performance of cellulose nanocrystals. Nat. Rev. Mater. 2021, 6, 124–144. [Google Scholar] [CrossRef]
- Rivas, B.L.; Espinosa, C.; Sánchez, J. Application of the liquid-phase polymer-based retention technique to the sorption of molybdenum(VI) and vanadium(V). Polym. Bull. 2019, 76, 539–552. [Google Scholar] [CrossRef]
- Lienkamp, K.; Kumar, K.-N.; Som, A.; Nüsslein, K.; Tew, G.N. “Doubly Selective” Antimicrobial Polymers: How Do They Differentiate between Bacteria? Chem. Eur. J. 2009, 15, 11710–11714. [Google Scholar]
- Chen, Y.; Yu, L.; Zhang, B.; Feng, W.; Xu, M.; Gao, L.; Liu, N.; Wang, Q.; Huang, X.; Li, P.; et al. Design and synthesis of biocompatible, hemocompatible, and highly selective antimicrobial cationic peptidopolysaccharides via Click chemistry. Biomacromolecules 2019, 20, 2230–2240. [Google Scholar]
- Engler, A.C.; Wiradharma, N.; Ong, Z.Y.; Coady, D.J.; Hedrick, J.L.; Yang, Y.-Y. Emerging trends in macromolecular antimicrobials to fight multi-drug-resistant infections. Nano Today 2012, 7, 201–222. [Google Scholar]
- Noronha, V.T.; Jackson, J.C.; Camargos, C.H.M.; Paula, A.J.; Rezende, C.A.; Faria, A.F. “Attacking–Attacking” Anti-biofouling Strategy Enabled by Cellulose Nanocrystals–Silver Materials. ACS Appl. Bio Mater. 2022, 5, 1025–1037. [Google Scholar] [CrossRef]

| MIC1 (mg/mL) (Complete Inhibition) | MIC2 (mg/mL) (Partial Inhibition) | |||||
|---|---|---|---|---|---|---|
| SA | EC | PA | SA | EC | PA | |
| A | - | - | - | - | - | - |
| B | 0.62 | - | - | 0.62 | - | - |
| C | 1.25 | 3.50 * | - | 0.62 | 2.50 | 5.00 |
| D | 2.50 | 5.00 | - | 0.62 | 2.50 | - |
Disclaimer/Publisher’s Note: The statements, opinions and data contained in all publications are solely those of the individual author(s) and contributor(s) and not of MDPI and/or the editor(s). MDPI and/or the editor(s) disclaim responsibility for any injury to people or property resulting from any ideas, methods, instructions or products referred to in the content. |
© 2023 by the authors. Licensee MDPI, Basel, Switzerland. This article is an open access article distributed under the terms and conditions of the Creative Commons Attribution (CC BY) license (https://creativecommons.org/licenses/by/4.0/).
Share and Cite
Rabia, E.; Tuga, B.; Ondarza, J.d.; Ramos, S.M.; Lam, E.; Hrapovic, S.; Liu, Y.; Sunasee, R. Carboxylated Cellulose Nanocrystals Decorated with Varying Molecular Weights of Poly(diallyldimethylammonium chloride) as Sustainable Antibacterial Agents. Polymers 2023, 15, 865. https://doi.org/10.3390/polym15040865
Rabia E, Tuga B, Ondarza Jd, Ramos SM, Lam E, Hrapovic S, Liu Y, Sunasee R. Carboxylated Cellulose Nanocrystals Decorated with Varying Molecular Weights of Poly(diallyldimethylammonium chloride) as Sustainable Antibacterial Agents. Polymers. 2023; 15(4):865. https://doi.org/10.3390/polym15040865
Chicago/Turabian StyleRabia, Eliskander, Beza Tuga, José de Ondarza, Saleen M. Ramos, Edmond Lam, Sabahudin Hrapovic, Yali Liu, and Rajesh Sunasee. 2023. "Carboxylated Cellulose Nanocrystals Decorated with Varying Molecular Weights of Poly(diallyldimethylammonium chloride) as Sustainable Antibacterial Agents" Polymers 15, no. 4: 865. https://doi.org/10.3390/polym15040865
APA StyleRabia, E., Tuga, B., Ondarza, J. d., Ramos, S. M., Lam, E., Hrapovic, S., Liu, Y., & Sunasee, R. (2023). Carboxylated Cellulose Nanocrystals Decorated with Varying Molecular Weights of Poly(diallyldimethylammonium chloride) as Sustainable Antibacterial Agents. Polymers, 15(4), 865. https://doi.org/10.3390/polym15040865








